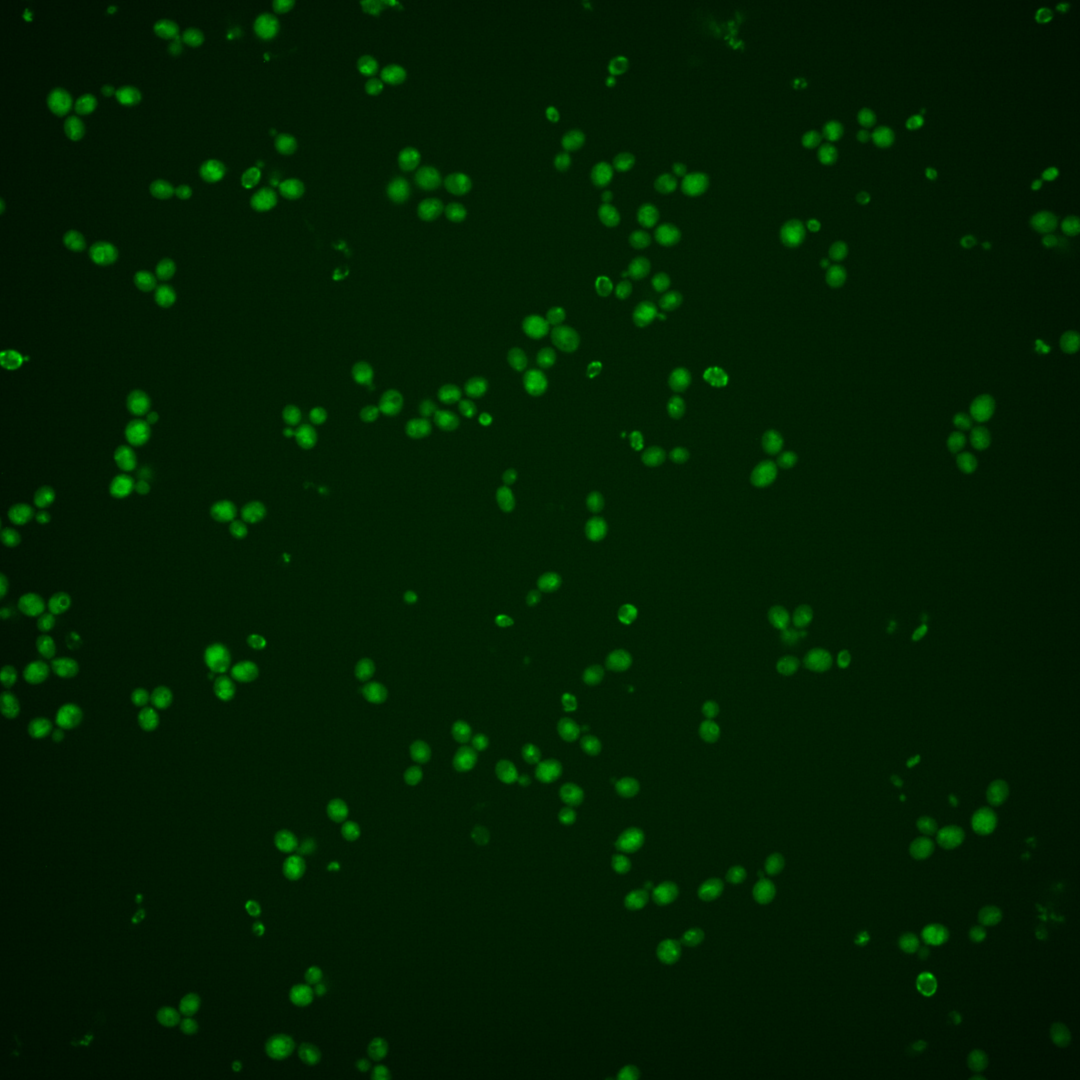
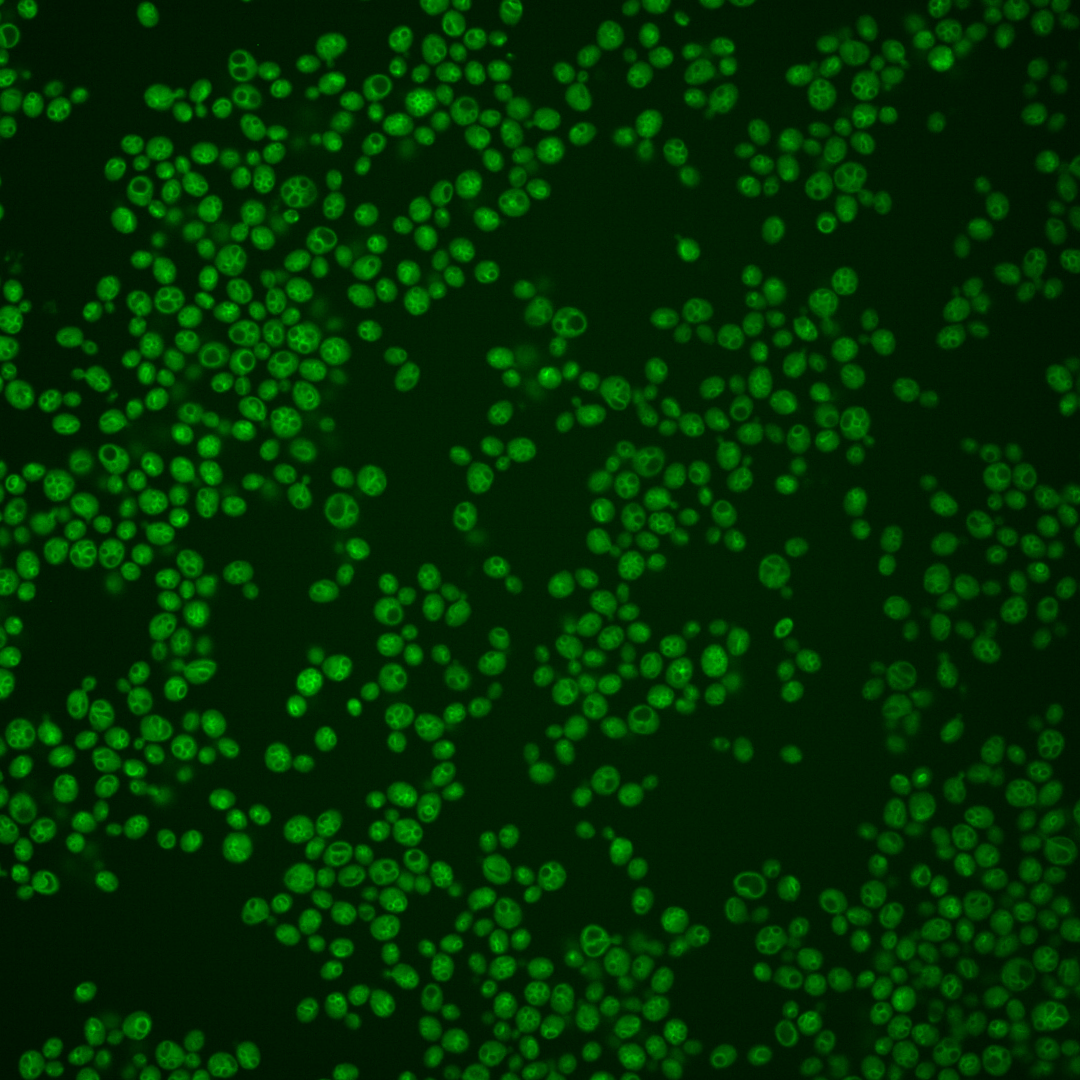
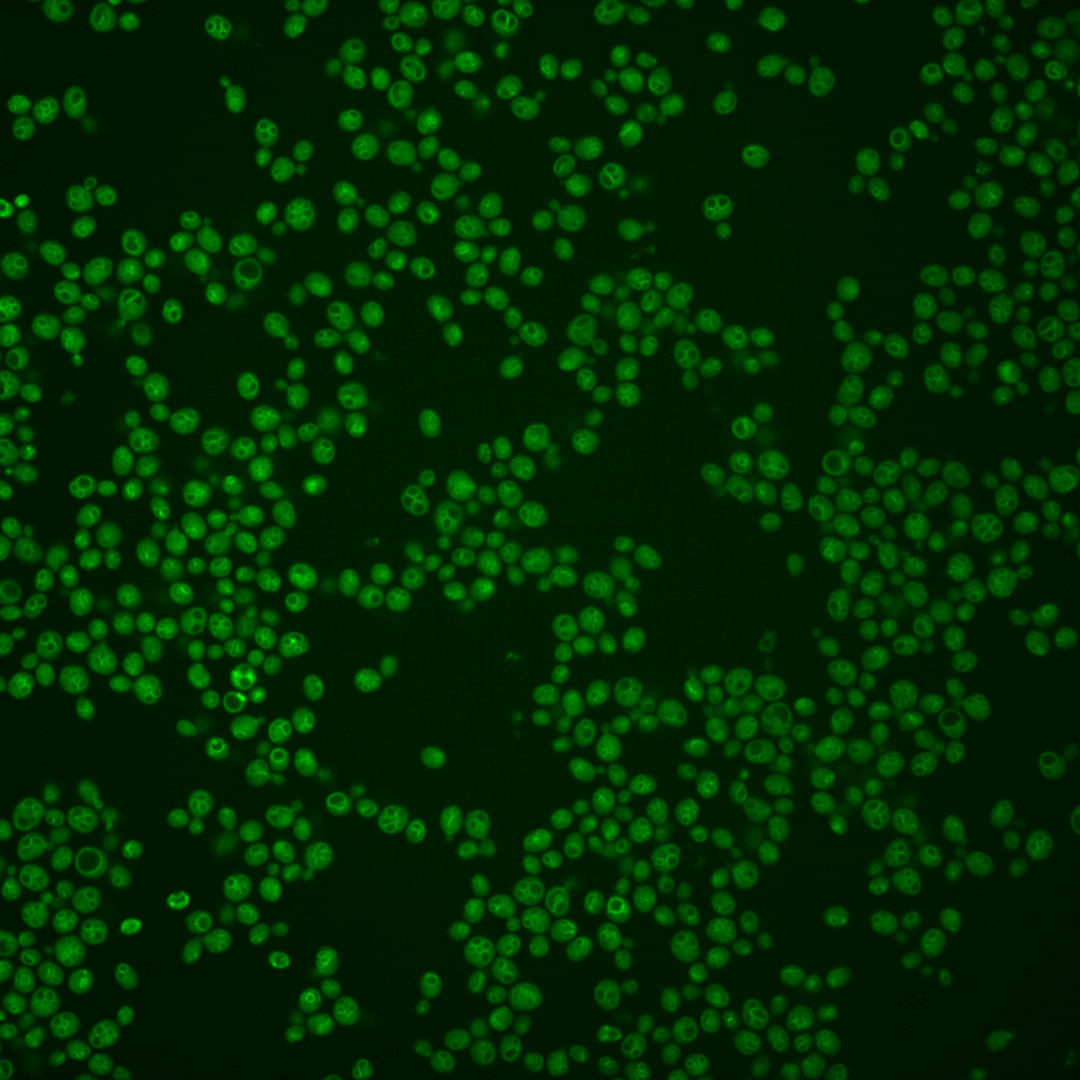

| Standard name | |
|---|---|
| Human Ortholog | |
| Description | Palmitoylated vacuolar membrane-localized casein kinase I isoform; negatively regulates vacuole fusion during hypertonic stress via phosphorylation of Vps41p; shares essential functions with Hrr25p; regulates vesicle fusion in AP-3 pathway |
Micrographs




















































































Sub-cellular Localization
Yeast GFP Assignment
Protein Abundance
Localization Change
External localization resources
| ensLOC | DeepLoc | |||||||||||||||||||||||
|---|---|---|---|---|---|---|---|---|---|---|---|---|---|---|---|---|---|---|---|---|---|---|---|---|
| Localization | WT1 | WT2 | WT3 | RAP60 | RAP140 | RAP220 | RAP300 | RAP380 | RAP460 | RAP540 | RAP620 | RAP700 | HU80 | HU120 | HU160 | rpd3Δ_1 | rpd3Δ_2 | rpd3Δ_3 | WT1 | WT2 | WT3 | AF100 | AF140 | AF180 |
| Cortical Patches | 0 | 0 | 2 | 0 | 0 | 0 | 0 | 0 | – | 0 | 0 | 0 | 0 | 0 | 0 | 0 | 0 | 0 | 0 | 0 | 1 | 0 | 0 | 2 |
| Bud | 1 | 1 | 1 | 1 | 0 | 0 | 2 | 2 | – | 1 | 1 | 0 | 0 | 0 | 0 | 0 | 0 | 0 | 5 | 7 | 4 | 5 | 4 | 10 |
| Bud Neck | 0 | 0 | 0 | 0 | 0 | 0 | 0 | 0 | – | 0 | 0 | 0 | 0 | 0 | 0 | 0 | 0 | 0 | 0 | 0 | 1 | 0 | 2 | 2 |
| Bud Site | 0 | 0 | 0 | 0 | 0 | 0 | 0 | 0 | – | 0 | 0 | 0 | 0 | 0 | 0 | 0 | 0 | 0 | – | – | – | – | – | – |
| Cell Periphery | 0 | 0 | 0 | 0 | 0 | 0 | 0 | 2 | – | 1 | 1 | 2 | 2 | 2 | 0 | 0 | 0 | 0 | 0 | 0 | 0 | 0 | 0 | 0 |
| Cytoplasm | 60 | 38 | 61 | 54 | 53 | 69 | 65 | 74 | – | 85 | 79 | 92 | 10 | 10 | 14 | 45 | 58 | 39 | 6 | 6 | 3 | 9 | 8 | 8 |
| Endoplasmic Reticulum | 1 | 5 | 11 | 9 | 0 | 14 | 11 | 8 | – | 12 | 3 | 3 | 1 | 1 | 3 | 15 | 18 | 9 | 1 | 0 | 2 | 2 | 4 | 5 |
| Endosome | 76 | 24 | 201 | 86 | 30 | 18 | 26 | 24 | – | 4 | 4 | 11 | 21 | 19 | 23 | 29 | 44 | 28 | 97 | 79 | 126 | 55 | 123 | 114 |
| Golgi | 0 | 0 | 4 | 13 | 6 | 8 | 1 | 1 | – | 0 | 0 | 0 | 1 | 1 | 2 | 3 | 4 | 14 | 3 | 2 | 2 | 0 | 0 | 1 |
| Mitochondria | 0 | 1 | 0 | 13 | 5 | 74 | 111 | 90 | – | 151 | 109 | 103 | 0 | 0 | 0 | 12 | 5 | 8 | 1 | 3 | 3 | 3 | 5 | 5 |
| Nucleus | 8 | 5 | 0 | 0 | 2 | 2 | 3 | 5 | – | 4 | 5 | 7 | 5 | 5 | 7 | 15 | 11 | 10 | 12 | 6 | 4 | 2 | 5 | 7 |
| Nuclear Periphery | 0 | 1 | 2 | 4 | 0 | 7 | 4 | 1 | – | 3 | 0 | 2 | 2 | 1 | 7 | 9 | 11 | 3 | 10 | 6 | 31 | 9 | 25 | 21 |
| Nucleolus | 15 | 9 | 18 | 7 | 0 | 1 | 0 | 3 | – | 1 | 2 | 0 | 7 | 7 | 6 | 5 | 15 | 8 | 3 | 2 | 0 | 0 | 3 | 6 |
| Peroxisomes | 0 | 0 | 0 | 0 | 0 | 0 | 0 | 0 | – | 0 | 0 | 0 | 0 | 0 | 0 | 0 | 0 | 0 | 0 | 0 | 0 | 0 | 0 | 1 |
| SpindlePole | 4 | 2 | 19 | 4 | 2 | 0 | 0 | 1 | – | 0 | 1 | 0 | 2 | 3 | 1 | 3 | 4 | 3 | 2 | 3 | 4 | 1 | 3 | 3 |
| Vac/Vac Membrane | 351 | 303 | 259 | 112 | 134 | 140 | 143 | 150 | – | 109 | 87 | 118 | 91 | 93 | 103 | 249 | 261 | 208 | 288 | 251 | 236 | 124 | 265 | 252 |
| Unique Cell Count | 413 | 348 | 414 | 230 | 203 | 260 | 298 | 309 | 291 | 231 | 281 | 115 | 116 | 129 | 313 | 334 | 264 | 436 | 375 | 425 | 219 | 455 | 449 | |
| Labelled Cell Count | 516 | 389 | 578 | 303 | 232 | 333 | 366 | 361 | 371 | 292 | 338 | 142 | 142 | 166 | 385 | 431 | 330 | 436 | 375 | 425 | 219 | 455 | 449 | |
Yeast GFP Assignment
Protein Abundance
| Screen | WT1 | WT2 | WT3 | RAP60 | RAP140 | RAP220 | RAP300 | RAP380 | RAP460 | RAP540 | RAP620 | RAP700 | HU80 | HU120 | HU160 | rpd3Δ_1 | rpd3Δ_2 | rpd3Δ_3 | AF100 | AF140 | AF180 |
|---|---|---|---|---|---|---|---|---|---|---|---|---|---|---|---|---|---|---|---|---|---|
| Mean Cell GFP Intensity (1e-4) | 9.8 | 9.0 | 8.6 | 8.1 | 8.0 | 6.3 | 6.2 | 6.4 | – | 5.7 | 5.8 | 6.1 | 9.9 | 9.9 | 9.7 | 8.7 | 10.0 | 10.3 | 9.9 | 10.1 | 10.6 |
| Std Deviation (1e-4) | 1.3 | 1.4 | 1.2 | 1.4 | 1.4 | 1.1 | 1.5 | 1.5 | – | 1.2 | 1.1 | 1.4 | 1.3 | 1.3 | 1.6 | 1.7 | 2.2 | 2.3 | 2.0 | 1.6 | 2.1 |
| Intensity Change (Log2) | – | – | – | -0.08 | -0.1 | -0.44 | -0.46 | -0.43 | – | -0.58 | -0.57 | -0.5 | 0.21 | 0.21 | 0.18 | 0.01 | 0.22 | 0.26 | 0.21 | 0.24 | 0.3 |
Localization Change
| Localization | RAP60 | RAP140 | RAP220 | RAP300 | RAP380 | RAP460 | RAP540 | RAP620 | RAP700 | HU80 | HU120 | HU160 | rpd3Δ_1 | rpd3Δ_2 | rpd3Δ_3 |
|---|---|---|---|---|---|---|---|---|---|---|---|---|---|---|---|
| Cortical Patches | 0 | 0 | 0 | 0 | 0 | – | 0 | 0 | 0 | 0 | 0 | 0 | 0 | 0 | 0 |
| Bud | 0 | 0 | 0 | 0 | 0 | – | 0 | 0 | 0 | 0 | 0 | 0 | 0 | 0 | 0 |
| Bud Neck | 0 | 0 | 0 | 0 | 0 | – | 0 | 0 | 0 | 0 | 0 | 0 | 0 | 0 | 0 |
| Bud Site | 0 | 0 | 0 | 0 | 0 | – | 0 | 0 | 0 | 0 | 0 | 0 | 0 | 0 | 0 |
| Cell Periphery | 0 | 0 | 0 | 0 | 0 | – | 0 | 0 | 0 | 0 | 0 | 0 | 0 | 0 | 0 |
| Cytoplasm | 2.8 | 3.4 | 3.8 | 2.4 | 3.1 | – | 4.7 | 5.7 | 5.6 | -1.7 | -1.7 | -1.1 | -0.1 | 1.0 | 0 |
| Endoplasmic Reticulum | 0.9 | 0 | 1.8 | 0.8 | -0.1 | – | 1.1 | -1.1 | -1.5 | 0 | 0 | 0 | 1.5 | 1.9 | 0.6 |
| Endosome | -2.7 | -8.1 | -11.2 | -11.2 | -11.7 | – | -13.6 | -12.2 | -12.5 | -5.8 | -6.2 | -6.2 | -11.3 | -10.2 | -10.2 |
| Golgi | 3.6 | 0 | 0 | 0 | 0 | – | 0 | 0 | 0 | 0 | 0 | 0 | 0 | 0 | 3.4 |
| Mitochondria | 0 | 0 | 11.5 | 13.5 | 11.7 | – | 16.5 | 15.3 | 13.3 | 0 | 0 | 0 | 4.0 | 0 | 0 |
| Nucleus | 0 | 0 | 0 | 0 | 0 | – | 0 | 0 | 0 | 0 | 0 | 0 | 4.5 | 0 | 0 |
| Nuclear Periphery | 0 | 0 | 0 | 0 | 0 | – | 0 | 0 | 0 | 0 | 0 | 0 | 0 | 2.9 | 0 |
| Nucleolus | -0.8 | -3.0 | -3.0 | -3.6 | -2.7 | – | -3.2 | -2.4 | -3.5 | 0.8 | 0.8 | 0.1 | -2.1 | 0.1 | -0.9 |
| Peroxisomes | 0 | 0 | 0 | 0 | 0 | – | 0 | 0 | 0 | 0 | 0 | 0 | 0 | 0 | 0 |
| SpindlePole | -1.9 | -2.3 | -3.5 | -3.7 | -3.5 | – | -3.7 | -2.9 | -3.6 | 0 | 0 | 0 | -2.8 | -2.7 | -2.5 |
| Vacuole | -3.4 | 0.8 | -2.2 | -3.9 | -3.8 | – | -6.6 | -6.1 | -5.3 | 3.3 | 3.5 | 3.6 | 4.9 | 4.6 | 4.5 |
External localization resources
Images






























Protein Concentration and Protein Localization Data
| R1 | R2 | R3 | ||||||||||||||||
|---|---|---|---|---|---|---|---|---|---|---|---|---|---|---|---|---|---|---|
| G1 Pre-START | G1 Post-START | S/G2 | Metaphase | Anaphase | Telophase | G1 Pre-START | G1 Post-START | S/G2 | Metaphase | Anaphase | Telophase | G1 Pre-START | G1 Post-START | S/G2 | Metaphase | Anaphase | Telophase | |
| Concentration | 7.0277 | 6.3403 | 5.9014 | 5.8189 | 5.8536 | 6.4771 | 8.4626 | 9.5571 | 8.8926 | 8.237 | 8.9274 | 8.9861 | 8.6093 | 10.1935 | 9.5741 | 9.284 | 8.9746 | 9.4157 |
| Actin | 0.0117 | 0.0002 | 0.0008 | 0.0001 | 0 | 0.0002 | 0.0257 | 0 | 0.013 | 0.0252 | 0.0037 | 0.0055 | 0 | 0 | 0 | 0 | 0 | 0 |
| Bud | 0.0013 | 0.0035 | 0.0021 | 0.0002 | 0.0005 | 0.0053 | 0.001 | 0.0004 | 0.0017 | 0.0004 | 0.0004 | 0.0004 | 0.0005 | 0.0002 | 0.0004 | 0.0002 | 0.0004 | 0.0003 |
| Bud Neck | 0.0012 | 0.0007 | 0.0025 | 0.0009 | 0.0003 | 0.0038 | 0.0012 | 0.0008 | 0.0012 | 0.0002 | 0.0005 | 0.0014 | 0.0007 | 0.0004 | 0.0029 | 0.0001 | 0.0005 | 0.0008 |
| Bud Periphery | 0.0021 | 0.0027 | 0.0017 | 0.0002 | 0.0004 | 0.0034 | 0.0014 | 0.0003 | 0.0016 | 0.0003 | 0.0002 | 0.0004 | 0.0007 | 0.0002 | 0.0005 | 0.0002 | 0.0002 | 0.0004 |
| Bud Site | 0.0014 | 0.0076 | 0.0056 | 0.0005 | 0.0007 | 0.0032 | 0.0015 | 0.0017 | 0.0048 | 0.0009 | 0.0004 | 0.0006 | 0.0032 | 0.0006 | 0.0013 | 0.0001 | 0.0011 | 0.0005 |
| Cell Periphery | 0.0007 | 0.0006 | 0.0005 | 0.0002 | 0.0002 | 0.0028 | 0.0005 | 0.0004 | 0.0004 | 0.0001 | 0.0001 | 0.0001 | 0.0004 | 0.0003 | 0.0003 | 0.0001 | 0.0001 | 0.0006 |
| Cytoplasm | 0.0248 | 0.0898 | 0.0644 | 0.0347 | 0.0203 | 0.0379 | 0.0723 | 0.099 | 0.1278 | 0.0722 | 0.0732 | 0.1059 | 0.0151 | 0.0292 | 0.0184 | 0.0123 | 0.0113 | 0.021 |
| Cytoplasmic Foci | 0.0196 | 0.0196 | 0.0207 | 0.0264 | 0.0132 | 0.0264 | 0.0364 | 0.0119 | 0.0305 | 0.0116 | 0.0171 | 0.0333 | 0.0096 | 0.0062 | 0.01 | 0.008 | 0.0073 | 0.013 |
| Eisosomes | 0.0001 | 0 | 0 | 0 | 0 | 0 | 0.0002 | 0 | 0.0001 | 0 | 0 | 0 | 0 | 0 | 0 | 0 | 0 | 0 |
| Endoplasmic Reticulum | 0.0074 | 0.004 | 0.0053 | 0.005 | 0.0011 | 0.0096 | 0.0147 | 0.0107 | 0.0086 | 0.0022 | 0.0037 | 0.0065 | 0.005 | 0.0098 | 0.0059 | 0.0033 | 0.0016 | 0.0041 |
| Endosome | 0.261 | 0.1543 | 0.2304 | 0.2141 | 0.2201 | 0.2108 | 0.3375 | 0.1808 | 0.289 | 0.344 | 0.283 | 0.2998 | 0.2734 | 0.1797 | 0.2375 | 0.298 | 0.2303 | 0.2141 |
| Golgi | 0.0055 | 0.0021 | 0.0043 | 0.0057 | 0.0023 | 0.0033 | 0.0193 | 0.0016 | 0.0144 | 0.0044 | 0.0059 | 0.0142 | 0.0033 | 0.0018 | 0.0047 | 0.0017 | 0.0023 | 0.0038 |
| Lipid Particles | 0.0068 | 0.0022 | 0.0039 | 0.0083 | 0.0004 | 0.0018 | 0.0166 | 0.0006 | 0.0038 | 0.0009 | 0.0154 | 0.0036 | 0.0124 | 0.0024 | 0.0017 | 0.0017 | 0.0011 | 0.003 |
| Mitochondria | 0.0213 | 0.0027 | 0.0038 | 0.0096 | 0.0003 | 0.0012 | 0.0238 | 0.0005 | 0.0153 | 0.0021 | 0.0008 | 0.0053 | 0.0014 | 0.0004 | 0.0018 | 0.0024 | 0.0002 | 0.0007 |
| None | 0.0412 | 0.0238 | 0.0561 | 0.0012 | 0.0001 | 0.0063 | 0.0029 | 0.0004 | 0.0014 | 0.0009 | 0.0007 | 0.0008 | 0.0002 | 0.0001 | 0.0001 | 0.0001 | 0.0001 | 0.0002 |
| Nuclear Periphery | 0.0257 | 0.0303 | 0.0151 | 0.0147 | 0.0058 | 0.0353 | 0.0194 | 0.0366 | 0.0124 | 0.0059 | 0.0072 | 0.0179 | 0.0236 | 0.0289 | 0.0349 | 0.0151 | 0.0058 | 0.0159 |
| Nucleolus | 0.0093 | 0.0034 | 0.0035 | 0.0007 | 0.0005 | 0.0013 | 0.0008 | 0.0018 | 0.0004 | 0.0003 | 0.0004 | 0.0007 | 0.0038 | 0.0085 | 0.0022 | 0.0002 | 0.0004 | 0.0018 |
| Nucleus | 0.0156 | 0.0267 | 0.017 | 0.0196 | 0.0021 | 0.0163 | 0.0255 | 0.0082 | 0.0054 | 0.0021 | 0.003 | 0.0099 | 0.0035 | 0.004 | 0.0043 | 0.0014 | 0.0025 | 0.0046 |
| Peroxisomes | 0.0043 | 0.0014 | 0.0014 | 0.0162 | 0.0003 | 0.0005 | 0.004 | 0.0001 | 0.0073 | 0.0033 | 0.0071 | 0.0018 | 0.0004 | 0.0001 | 0.0002 | 0 | 0.0001 | 0.0003 |
| Punctate Nuclear | 0.0093 | 0.0012 | 0.003 | 0.0007 | 0.0001 | 0.0065 | 0.0015 | 0.0002 | 0.0008 | 0.0028 | 0.0007 | 0.0018 | 0.0003 | 0.0005 | 0.0005 | 0 | 0.0001 | 0.002 |
| Vacuole | 0.4362 | 0.5104 | 0.417 | 0.4772 | 0.4871 | 0.4506 | 0.312 | 0.5236 | 0.377 | 0.3778 | 0.4109 | 0.3767 | 0.4803 | 0.4793 | 0.4253 | 0.4152 | 0.5103 | 0.4782 |
| Vacuole Periphery | 0.0934 | 0.1129 | 0.1408 | 0.164 | 0.2442 | 0.1738 | 0.0817 | 0.1205 | 0.0832 | 0.1422 | 0.1654 | 0.1132 | 0.1624 | 0.2472 | 0.2469 | 0.2399 | 0.2245 | 0.2347 |
Sequencing Data
| R1 | R2 | |||||||||
|---|---|---|---|---|---|---|---|---|---|---|
| G1 Post-START | S/G2 | Metaphase | Anaphase | Telophase | G1 Post-START | S/G2 | Metaphase | Anaphase | Telophase | |
| Gene Expression | 16.1132 | 19.4144 | 15.3358 | 25.9629 | 19.529 | 10.5028 | 22.6377 | 20.9417 | 21.7513 | 27.86 |
| Translational Efficiency | 1.2816 | 1.0625 | 1.2713 | 0.8359 | 1.0066 | 1.9649 | 1.0097 | 1.064 | 1.0545 | 0.8955 |
Hit Data
| Dataset | Hit |
|---|---|
| Protein Concentration | ✘ |
| Protein Localization | ✘ |
| Gene Expression | ✘ |
| Translational Efficiency | ✘ |
Endocytosis
| Temp | Actin Patch (Sac6-tdTomato) | Cortical Patch (Sla1-GFP) | Late Endosome (Snf7-GFP) | Vacuole (Vph1-GFP) |
|---|---|---|---|---|
| 37℃ | ||||
| RT |
Cell Cycle Omics
CYCLoPs (Yck3-GFP)
| Gene / Allele | Actin Patch (Sac6-tdTomato) | Cortical Patch (Sla1-GFP) | Late Endosome (Snf7-GFP) | Vacuole (Sac6-tdTomato) |
|---|
| Gene | Images |
|---|
| Gene | Images |
|---|
Images are not yet available
Images are not yet available